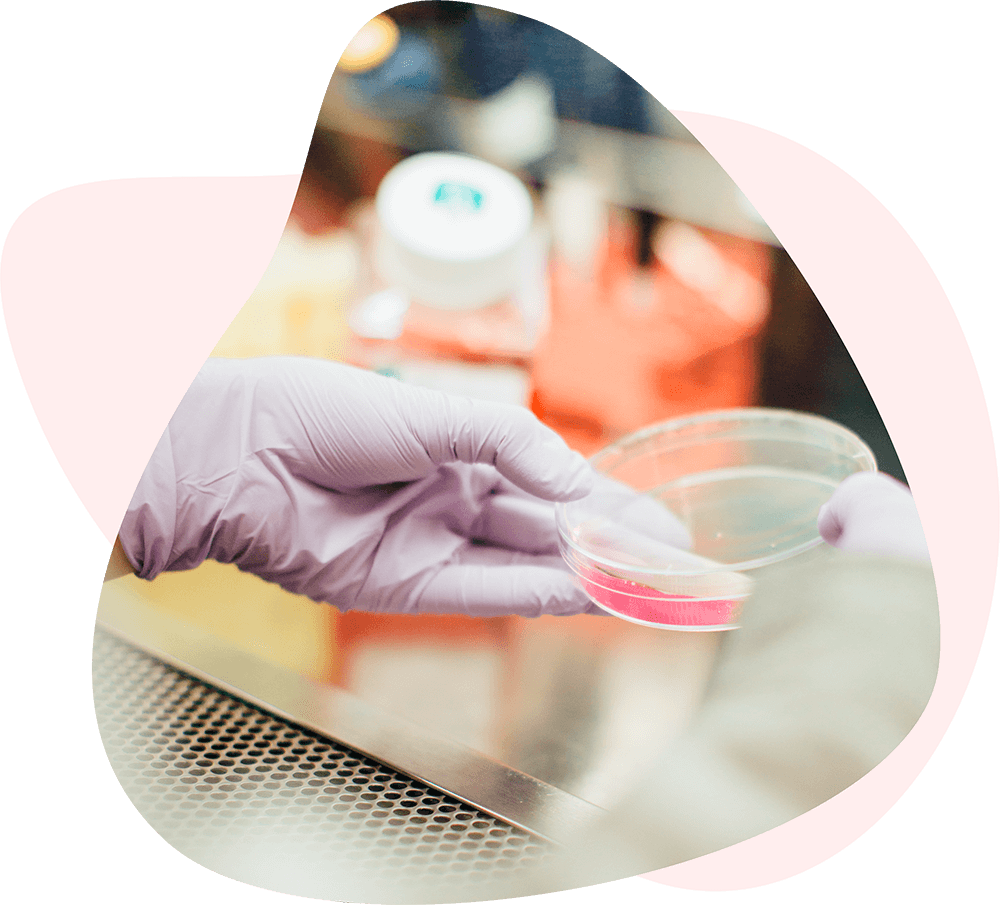
5 1

El método ProGen es un tratamiento médico para perder peso y mejorar la composición corporal según tu perfil genético. Está basado por un lado, en la dieta cetogénica a medida y, por otro, en la reeducación de los hábitos alimenticios.
Ayudarte a perder peso es sólo el primer paso para aprender a alimentarte de forma saludable y mejorar tu vida y bienestar para siempre.

El método ProGen es un tratamiento médico para perder peso y mejorar la composición corporal según tu perfil genético. Está basado por un lado, en la dieta cetogénica a medida y, por otro, en la reeducación de los hábitos alimenticios.
Ayudarte a perder peso es sólo el primer paso para aprender a alimentarte de forma saludable y mejorar tu vida y bienestar para siempre.

La dieta cetogenica para la perdida de peso.
Las dietas cetogénicas bajas en grasas permiten perder peso de forma rápida y eficaz, gracias a la cetosis, que es la capacidad del cuerpo para utilizar las grasas en lugar de los hidratos de carbono (glúcidos) cuando éstas faltan. Dado su bajo contenido calórico es imprescindible que incluyan todos los requerimientos diarios de micronutrientes esenciales.
Los alimentos del Metodo ProGen están compuestos por proteínas de alta calidad y permiten llevar a cabo una dieta cetogénica mediante la ingesta de los nutrientes necesarios y sin pasar hambre.
Según la normativa actual, el contenido proteico debe proporcionar entre un 25-50% del valor energético del producto sin superar los 125 gr de proteína al día, y ésta debe ser de alta calidad biológica. Las ventajas intrínsecas de esta propuesta son asegurar el balance nitrogenado, evitar una disminución excesiva del metabolismo basal y promover el mantenimiento de la masa muscular.
La dieta cetogenica para la perdida de peso.
Las dietas cetogénicas bajas en grasas permiten perder peso de forma rápida y eficaz, gracias a la cetosis, que es la capacidad del cuerpo para utilizar las grasas en lugar de los hidratos de carbono (glúcidos) cuando éstas faltan. Dado su bajo contenido calórico es imprescindible que incluyan todos los requerimientos diarios de micronutrientes esenciales.
Los alimentos del Metodo ProGen están compuestos por proteínas de alta calidad y permiten llevar a cabo una dieta cetogénica mediante la ingesta de los nutrientes necesarios y sin pasar hambre.
Según la normativa actual, el contenido proteico debe proporcionar entre un 25-50% del valor energético del producto sin superar los 125 gr de proteína al día, y ésta debe ser de alta calidad biológica. Las ventajas intrínsecas de esta propuesta son asegurar el balance nitrogenado, evitar una disminución excesiva del metabolismo basal y promover el mantenimiento de la masa muscular.

Nutrigenètica al servicio de la salud.
El estudio de genes y nutrientes en cada individuo permite el desarrollo de estrategias nutricionales personalizadas, gracias a la nutrigenética y la nutrigenómica. La nutrigenética va del gen al nutriente mientras que la nutrigenómica va del nutriente al gen. Por ello, la variabilidad genética interindividual es un determinante crítico en los diferentes requerimientos nutricionales de cada persona, así como de la respuesta a diferentes factores ambientales relacionados. Es una prueba no invasiva que el médico realiza en la consulta y que no lleva más de 2 minutos realizar. Consiste en tomar una muestra de saliva que el propio paciente puede tomar y se realiza una vez de por vida, ya que los genes no cambian. Pueden activarse o desactivarse por factores ambientales (Factores epigenéticos), por lo que los genes están presentes desde la concepción aunque su efecto se manifieste tardíamente en la edad adulta, como por ejemplo en la diabetes.

Alimentos ProGen, proteinas esenciales para tu cuerpo.
Los alimentos del Metodo ProGen forman parte del tratamiento médico para ayudarte a mejorar su composición corporal. Hemos creado una gama de alimentos proteicos de alta calidad para ayudarle a perder peso sin perder demasiado muscular.
Te garantizan el aporte de proteínas de alto valor biológico para mantener las funciones fisiológicas del organismo y evitar la pérdida de la masa muscular.
En la fase de mantenimiento te ayudan a mantener tu peso a largo plazo.

App ProGen.
Junto al tratamiento médico, hemos creado una app para ayudarte y motivarte. Una herramienta con la que podrás realizar seguimiento de tu tratamiento o encontrar ejercicios a tu medida.
Además, ponemos a su disposición un acompañamiento real de nuestros profesionales desde el primer día, gracias a las consultas telefónicas o vía Whatsapp.
Evidentemente no todos tenemos las mismas necesidades, de ahí la importancia de un programa personalizado. Ven a consultarnos y te informaremos personalmente.
Ramón i Cajal 4 Altell 2 25003 Lleida Tf: 630 88 15 67